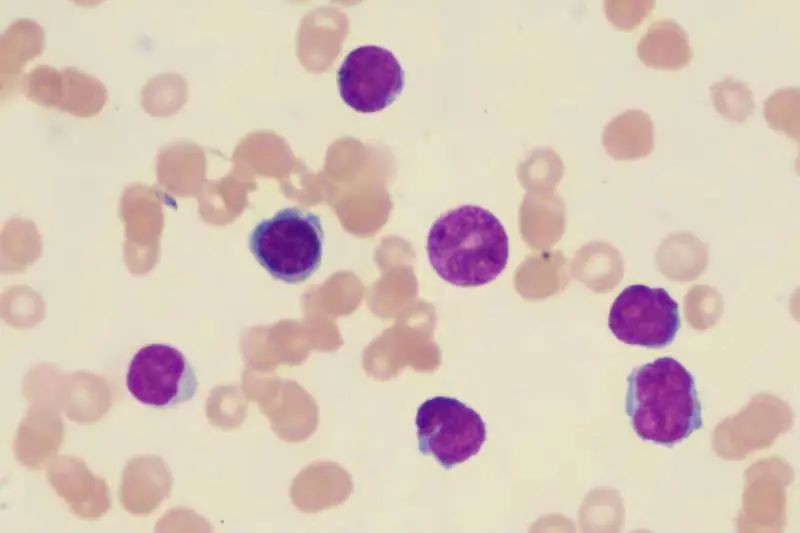
从「急淋」到「淋巴瘤」，揭秘鲜为人知的「隐形」侦探

医院里,有一群神秘人,他们每天和仪器、试管「打交道」,「与世隔绝」专注于微观世界,对着长相各异的细胞指指点点,他们是所有人都听过、但又不甚了解的「检验人」,他们都在忙乎啥呢?」所谓诊疗,即「诊断治疗」

医院里,有一群神秘人,他们每天和仪器、试管「打交道」,「与世隔绝」专注于微观世界,对着长相各异的细胞指指点点,他们是所有人都听过、但又不甚了解的「检验人」,他们都在忙乎啥呢?」
所谓诊疗,即「诊断治疗」,诊断准确才能治疗有效,医生的诊疗方案,「检验人」的一张张检验报告至关重要。
下面,一名患者的诊疗经历说明:「检验牛人」的加持对血液病精准诊断有多么重要。
这是一位中年女性患者,一年半前在当地医院诊断为「急性 B 细胞性淋巴细胞白血病」,采用急淋的标准 VDP 方案治疗,因疗效不佳入上海闸新中西医结合医院,经过上海闸新中西医结合医院检验人对原发病的精准评估,修正诊断为「弥漫大 B 细胞淋巴瘤,淋巴瘤白血病」,调整诱导治疗方案并针对性予自体干细胞移植巩固,至今原发病深度缓解无病生存。
如何发现患者是
「淋巴瘤」而非「急淋」?
血液病的诊断高度依赖骨髓形态学、免疫学、细胞遗传学以及分子生物学。初诊时,依据骨髓形态学结果,诊断为「急性淋巴细胞白血病「,并按照急性淋巴细胞白血病标准治疗,疾病持续不能控制,病人焦急万分,转入上海闸新中西医结合医院,临床与检验人反复沟通,结合形态学、尤其是「坏细胞」的免疫表型及其他特殊检验结果,修正诊断为「弥漫大 B 细胞淋巴瘤,淋巴瘤白血病」,并以此为依据,调整诊疗方案,一程化疗疾病就获得深度缓解。

骨髓涂片中异常细胞占 46.0%,此类细胞胞体相对略偏大,多呈类圆形或圆形,胞浆量相对偏少染灰蓝色,胞核多呈类圆形及扭曲凹陷形,部分细胞可见明显核切迹,核染色质相对疏松,隐约至明显可见 1-2 个核仁残迹,形态上与典型的急淋白血病细胞尚有区别。
然而,好景不长,常规腰穿脑脊液甩片再次发现不典型淋巴细胞,患者无任何中枢累及症状,临床与检验人反复沟通,考虑淋巴瘤中枢累及,再次调整治疗策略,选用可以穿透血脑屏障的药物。经过 2 程治疗,颅内以及外周肿瘤彻底清除,肿瘤细胞对化疗敏感,进一步予自体造血干细胞移植巩固,疾病持续深度的缓解,长期无病生存。
血液病的精准诊治背后
是一张张的 「检验报告」
血液病有效治疗方案的确定,高度依赖实验室、检验人的 MICM 分型。即通过细胞形态学(Morphology)、细胞免疫学(Immunology)、细胞遗传学(Cytogenetics)、分子生物学(Molecular biology)全方位多层次对白血病进行诊断分型,并提示预后,指导治疗,诊断的准确性直接决定治疗的有效性。




他们是「隐形」侦探,
是医疗战线上的「福尔摩斯」。
神秘的「实验室」中,检验人全神贯注于微观世界的观察,不断寻找各种疾病的致病原因,无数次的实验、培养和检测才凝聚成临床上的一份完整、精确的诊断报告。
血液病的精准诊治离不开实验室的神力加持。即便不为众人所熟知,检验科的「福尔摩斯」们依然每天奋战在一线,用它们敏锐的嗅觉,智慧的头脑,为救治患者而不断努力。他们,是「隐形」的侦探,隐秘而伟大!
好文章,需要你的鼓励
















